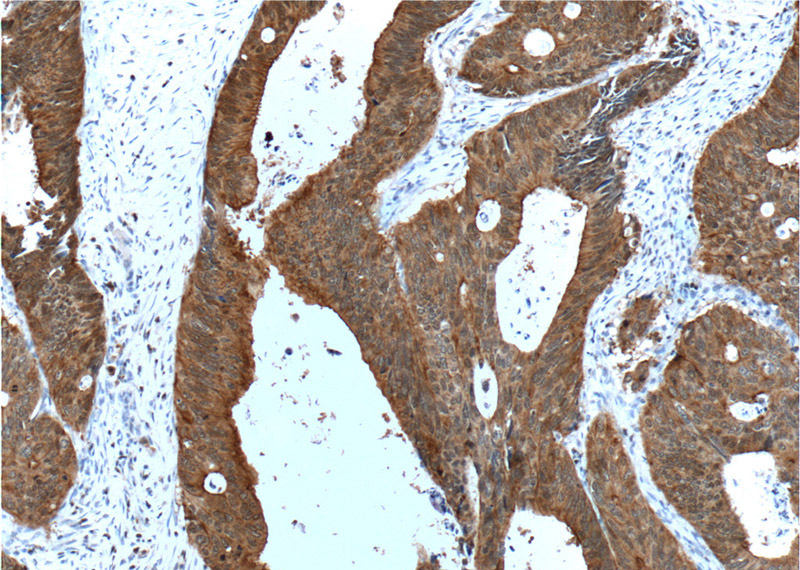
Immunohistochemistry of paraffin-embedded human colon cancer tissue slide using Catalog No:107539(VIL1 Antibody) at dilution of 1:500 (under 10x lens). heat mediated antigen retrieved with Tris-EDTA buffer(pH9).
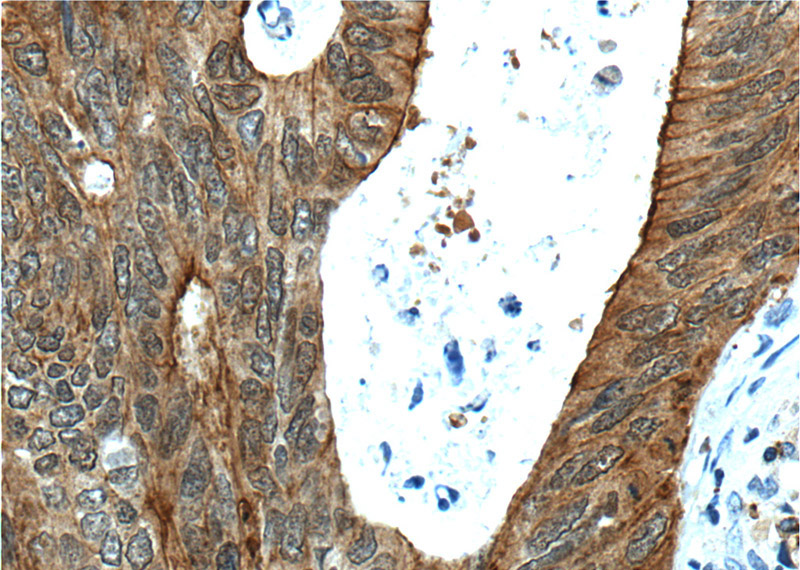
Immunohistochemistry of paraffin-embedded human colon cancer tissue slide using Catalog No:107539(VIL1 Antibody) at dilution of 1:500 (under 40x lens). heat mediated antigen retrieved with Tris-EDTA buffer(pH9).

-
Product Name
Villin antibody
- Documents
-
Description
Villin Mouse Monoclonal antibody. Positive WB detected in Human kidney. Positive IP detected in mouse kidney tissue. Positive IHC detected in human colon cancer tissue, human small intestine tissue. Positive IF detected in HepG2 cells. Observed molecular weight by Western-blot: 93-95 kDa
-
Tested applications
ELISA, WB, IF, IP, IHC
-
Species reactivity
Human, Mouse; other species not tested.
-
Alternative names
VIL antibody; VIL1 antibody; Villin antibody; villin 1 antibody
- Immunogen
-
Isotype
Mouse IgG1
-
Preparation
This antibody was obtained by immunization of Villin recombinant protein (Accession Number: BC017303). Purification method: Protein G purified.
-
Clonality
Monoclonal
-
Formulation
PBS with 0.02% sodium azide and 50% glycerol pH 7.3.
-
Storage instructions
Store at -20℃. DO NOT ALIQUOT
-
Applications
Recommended Dilution:
WB: 1:500-1:5000
IP: 1:500-1:5000
IHC: 1:20-1:200
IF: 1:10-1:100
-
Validations

human kidney tissue were subjected to SDS PAGE followed by western blot with Catalog No:107539(VIL1 antibody) at dilution of 1:1000

IP Result of anti-VIL1 (IP:Catalog No:107539, 4ug; Detection:Catalog No:107539 1:1000) with mouse kidney tissue lysate 6000ug.

Immunofluorescent analysis of HepG2 cells, using VIL1 antibody Catalog No: at 1:25 dilution and Rhodamine-labeled goat anti-mouse IgG (red).
Immunohistochemistry of paraffin-embedded human colon cancer tissue slide using Catalog No:107539(VIL1 Antibody) at dilution of 1:500 (under 10x lens). heat mediated antigen retrieved with Tris-EDTA buffer(pH9).
Immunohistochemistry of paraffin-embedded human colon cancer tissue slide using Catalog No:107539(VIL1 Antibody) at dilution of 1:500 (under 40x lens). heat mediated antigen retrieved with Tris-EDTA buffer(pH9).
-
Background
Villin 1 (VIL1) is a 95-kd F-actin bundling and severing protein and its expression is restricted to epithelial cells with a brush border, like epithelial cells of the intestinal mucosa, gall bladder, renal proximal tubules and ductuli efferentes of the testis. VIL1 has been reported to be an epithelial cell-specific anti-apoptotic protein, and to have an important function in regulating actin dynamics, cell morphology, epithelial-to-mesenchymal transitions, cell migration and cell survival. In addition, VIL1 is a useful diagnostic marker for of various cancer, like cervical and endometrial adenocarcinomas, renal cell carcinoma. VIL1 was recently identified as a novel biomarker predictive for postoperative recurrence and poorer prognosis of high serum AFP associated HCC.
-
References
- Peng ZM, Yu W, Xie Y. A four actin-binding protein signature model for poor prognosis of patients with esophageal squamous cell carcinoma. International journal of clinical and experimental pathology. 7(9):5950-9. 2014.
Related Products / Services
Please note: All products are "FOR RESEARCH USE ONLY AND ARE NOT INTENDED FOR DIAGNOSTIC OR THERAPEUTIC USE"
